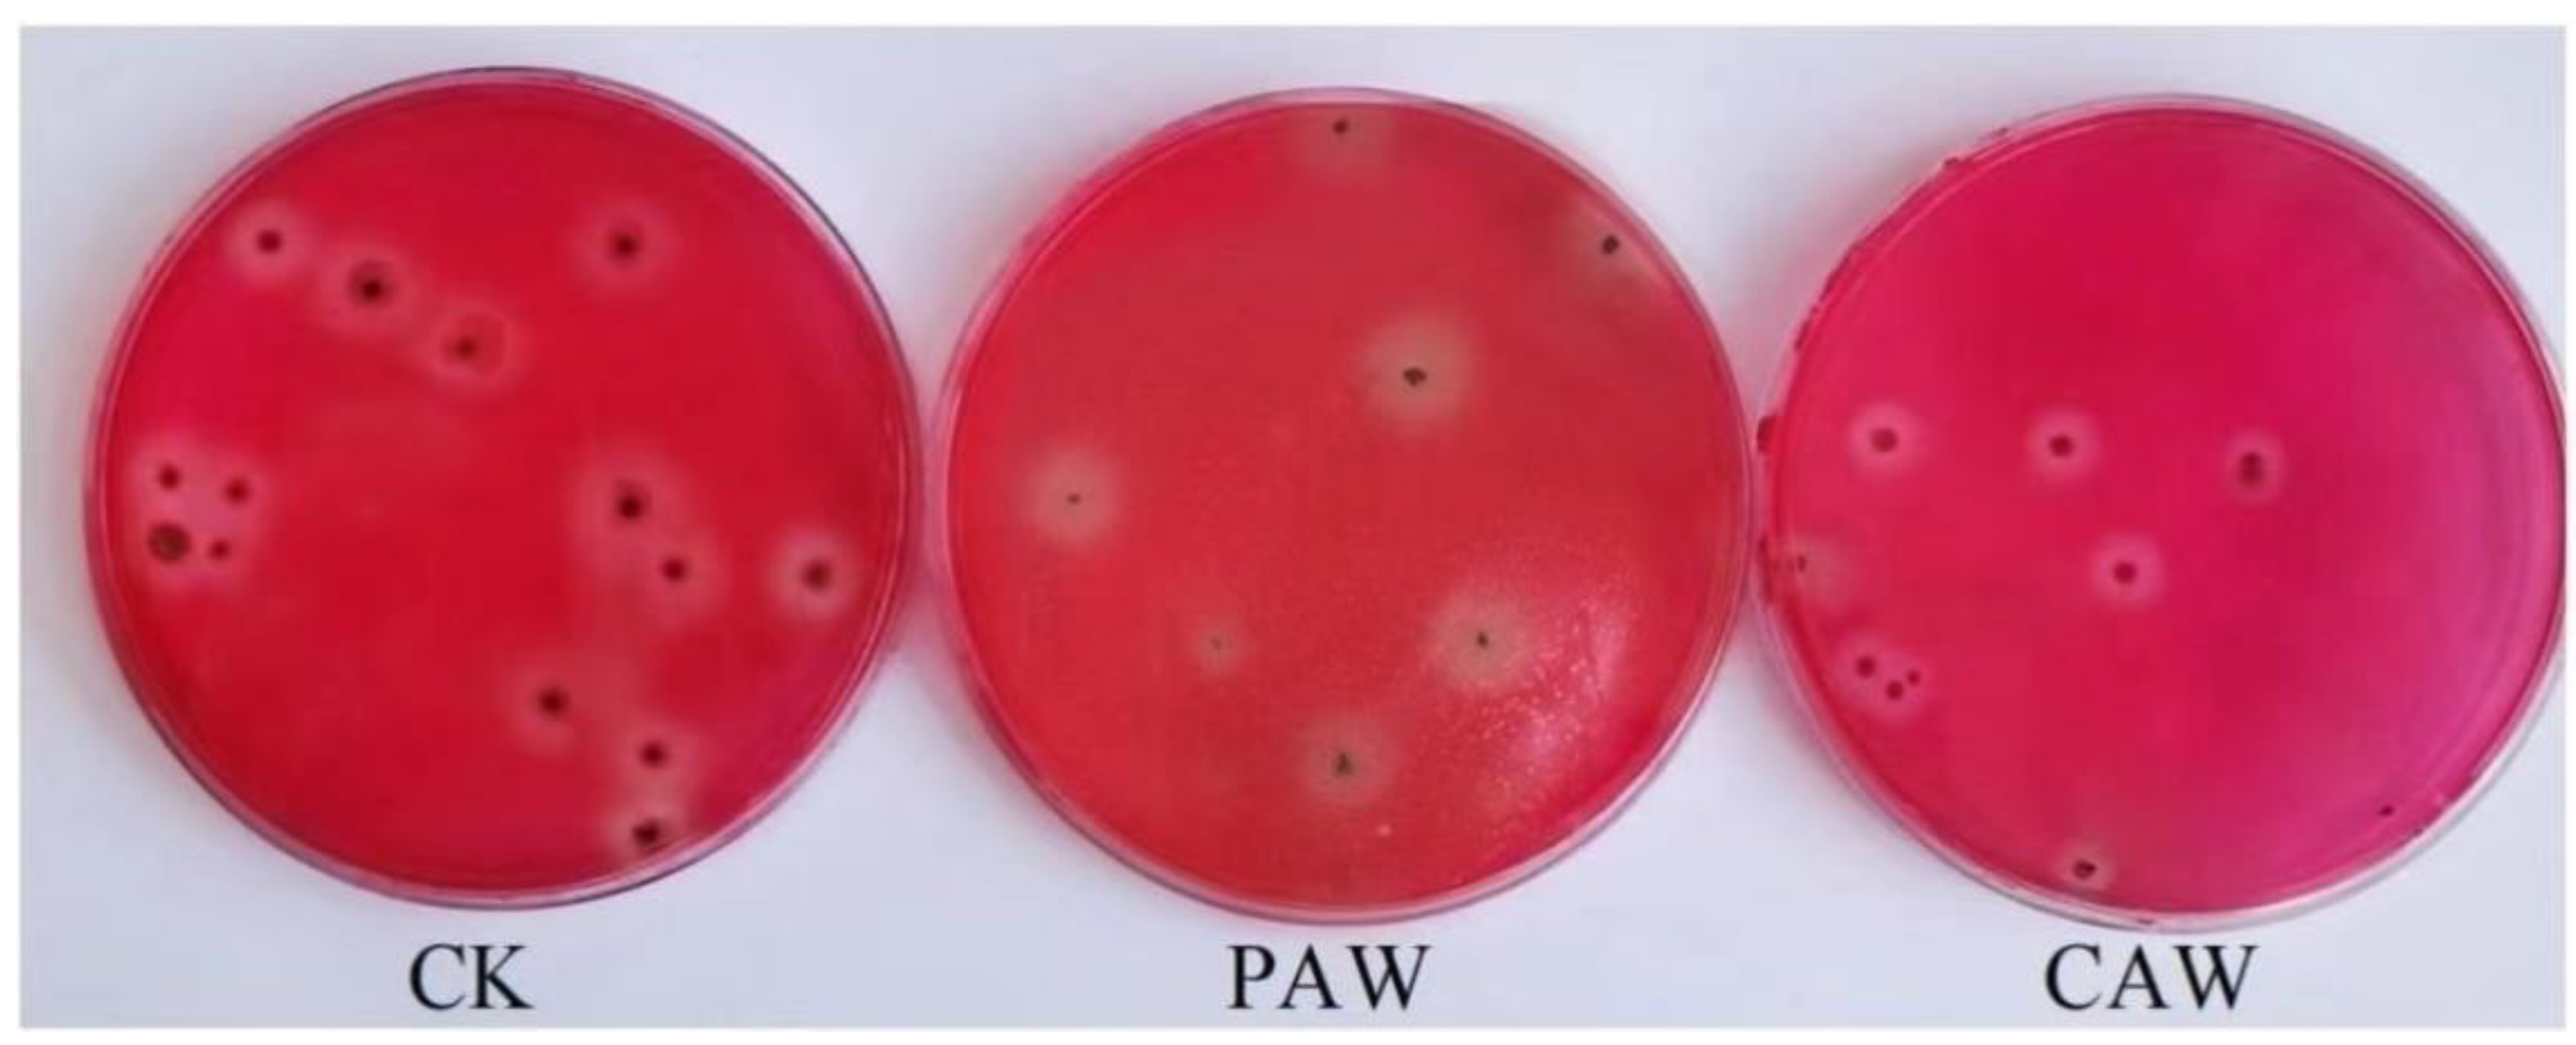
Jof 10 00568 g006

Effect of Plasma-Activated Water on the Cellulase-Producing Strain Aspergillus niger A32
Abstract
1. Introduction
2. Materials and Methods
2.1. Experimental Device
2.2. Preparation of Plasma-Activated Water and Determination of H2O2, NO2−, and NO3− Concentrations
2.3. Chemically Activated Water Preparation
2.4. pH/Conductivity/Redox Potential Determination for PAW and CAW
2.5. PAW and CAW Treatment and Probable Mutant Screening of A. niger A32
2.5.1. Strains
2.5.2. Main Reagents and Instruments
2.5.3. Culture Media
2.5.4. Preparation of Spore Suspensions of the Strain
2.5.5. PAW and CAW Treatment of A. niger A32
2.5.6. Screening of High-Yielding Cellulase Strains
2.5.7. Scanning Electron Microscopy (SEM) Measurements
2.5.8. Transmission Electron Microscopy (TEM) Measurements
2.5.9. Plotting of Glucose Standard Curves
2.5.10. Determination of Cellulase Activity
2.6. Gene Resequencing Analysis of Mutant and Wild Strains
2.7. Statistical Analysis
3. Results and Discussion
3.1. Concentration of Long-Lived Particles in Plasma-Activated Water
3.2. pH, Conductivity, and Redox Potential of PAW and CAW
3.3. Lethality of A. niger A32
3.4. Microstructural Changes in A. niger
3.5. Screening of A. niger A32 Probable Mutant Strains
3.6. Genome Resequencing Results and Analysis of Mutant Strains
4. Conclusions
Supplementary Materials
Author Contributions
Funding
Institutional Review Board Statement
Informed Consent Statement
Data Availability Statement
Conflicts of Interest
References
- Nowinski, D.; Czapka, T.; Maliszewska, I. Effect of multiple nonthermal plasma treatments of filamentous fungi on cellular phenotypic changes and phytopathogenicity. Int. J. Food Microbiol. 2024, 408, 110428. [Google Scholar] [CrossRef] [PubMed]
- Wang, T.; Wan, Q.G.; Xu, L.H.; Tian, L.P.; Cai, M.; Pu, L.M. Study on the bactericidal effect and mechanism of contact glow discharge plasma on Actinomucor elegans. J. Radiat. Res. Technol. 2022, 40, 40–50. [Google Scholar]
- Xu, H.; Fang, C.; Shao, C.; Li, L.; Huang, Q. Study of the synergistic effect of singlet oxygen with other plasma-generated ROS in fungi inactivation during water disinfection. Sci. Total Environ. 2022, 838, 156576. [Google Scholar] [CrossRef] [PubMed]
- Lunov, O.; Zablotskii, V.; Churpita, O.; Jäger, A.; Polívka, L.; Syková, E.; Terebova, N.; Kulikov, A.; Kubinová, S.; Dejneka, A. Towards the understanding of non-thermal air plasma action: Effects on bacteria and fibroblasts. RSC Adv. 2016, 6, 25286–25292. [Google Scholar] [CrossRef]
- Xu, H.; Liu, C.; Huang, Q. Enhance the inactivation of fungi by the sequential use of cold atmospheric plasma and plasma-activated water: Synergistic effect and mechanism study. Chem. Eng. J. 2023, 452, 139596. [Google Scholar] [CrossRef]
- Yao, Q.; Xu, H.; Zhuang, J.; Cui, D.; Ma, R.; Jiao, Z. Inhibition of Fungal Growth and Aflatoxin B1 Synthesis in Aspergillus flavus by Plasma-Activated Water. Foods 2023, 12, 2490. [Google Scholar] [CrossRef] [PubMed]
- Lin, C.-M.; Chu, Y.-C.; Hsiao, C.-P.; Wu, J.-S.; Hsieh, C.-W.; Hou, C.-Y. Optimization of plasma-activated water treatments to inactivate Salmonella Enteritidis (ATCC 13076) on shell eggs. Foods 2019, 8, 520. [Google Scholar] [CrossRef] [PubMed]
- Schuster, E.; Dunn-Coleman, N.; Frisvad, J.C.; Van Dijck, P.W.M. On the safety of Aspergillus niger—A review). Appl. Microbiol. Biotechnol. 2002, 59, 426–435. [Google Scholar] [PubMed]
- Yu, R.; Liu, J.; Wang, Y.; Wang, H.; Zhang, H. Aspergillus niger as a Secondary Metabolite Factory. Front. Chem. 2021, 9, 701022. [Google Scholar] [CrossRef]
- Li, Y.; Song, Z.; Zhang, T.; Xu, W.; Ding, C.; Chen, H. Spectral characteristics of needle array-plate dielectric barrier discharge plasma and its activated water. Spectrosc. 2021, 2021, 9771245. [Google Scholar] [CrossRef]
- Li, J.; Li, M.; Wang, L.; Zhou, H.; Zhang, X.; Fu, W.; Zou, W. Screening and identification of high cellulase-producing fungi and ultraviolet mutation selection study. Feed. Res. 2023, 46, 76–81. [Google Scholar]
- Xu, H.; Zhu, Y.; Du, M.; Wang, Y.; Ju, S.; Ma, R.; Jiao, Z. Subcellular mechanism of microbial inactivation during water disinfection by cold atmospheric-pressure plasma. Water Res. 2021, 188, 116513. [Google Scholar] [CrossRef] [PubMed]
- Huang, L.; Guo, L.; Qi, Y.; Chen, M.; Niyazi, G.; Yang, L.; Zhang, F.; Zhang, J.; Yao, Z.; Yan, J.; et al. Bactericidal effect of surface plasma under different discharge modes. Phys. Plasmas 2021, 28, 123501. [Google Scholar] [CrossRef]
- Bai, Y.; Muhammad, A.I.; Hu, Y.; Koseki, S.; Liao, X.; Chen, S.; Ye, X.; Liu, D.; Ding, T. Inactivation kinetics of Bacillus cereus spores by Plasma activated water (PAW). Food Res. Int. 2020, 131, 109041. [Google Scholar] [CrossRef] [PubMed]
- Charoux, C.M.G.; Patange, A.D.; Hinds, L.M.; Simpson, J.C.; O’Donnell, C.P.; Tiwari, B.K. Antimicrobial effects of airborne acoustic ultrasound and plasma activated water from cold and thermal plasma systems on biofilms. Sci. Rep. 2020, 10, 17297. [Google Scholar] [CrossRef] [PubMed]
- Royintarat, T.; Choi, E.H.; Boonyawan, D.; Seesuriyachan, P.; Wattanutchariya, W. Chemical-free and synergistic interaction of ultrasound combined with plasma-activated water (PAW) to enhance microbial inactivation in chicken meat and skin. Sci. Rep. 2020, 10, 1559. [Google Scholar] [CrossRef]
- Wang, H.; Zeng, X.F.; Feng, W.H.; Yu, L.M.; Zhai, W.J.; Bai, W.D.; Zeng, L.G. Antifungal Activity and Mechanism of Limonoids from Lemon Peel against Penicillium. Food Ferment. Ind. 2019, 45, 75–79. [Google Scholar]
- Simoncicova, J.; Kalinakova, B.; Kovacik, D.; Medvecka, V.; Lakatos, B.; Krystofova, S.; Hoppanova, L.; Paluskova, V.; Hudecova, D.; Durina, P.; et al. Cold plasma treatment triggers antioxidative defense system and induces changes in hyphal surface and subcellular structures of Aspergillus flavus. Appl. Microbiol. Biotechnol. 2018, 102, 6647–6658. [Google Scholar] [CrossRef]
- Xia, B.; Vyas, H.K.N.; Zhou, R.; Zhang, T.; Hong, J.; Rothwell, J.G.; Rice, S.A.; Carter, D.; Ostrikov, K.; Cullen, P.J.; et al. The importance of superoxide anion for Escherichia coli biofilm removal using plasma-activated water. J. Environ. Chem. Eng. 2023, 11, 109977. [Google Scholar] [CrossRef]
- Wong, K.S.; Chew, N.S.L.; Low, M.; Tan, M.K. Plasma-Activated Water: Physicochemical Properties, Generation Techniques, and Applications. Processes 2023, 11, 2213. [Google Scholar] [CrossRef]
- Rahman, M.; Hasan, M.S.; Islam, R.; Rana, R.; Sayem, A.; Sad, M.A.A.; Matin, A.; Raposo, A.; Zandonadi, R.P.; Han, H.; et al. Plasma-Activated Water for Food Safety and Quality: A Review of Recent Developments. Int. J. Environ. Res. Public Health 2022, 19, 6630. [Google Scholar] [CrossRef] [PubMed]
- Cheng, H.; Luo, J.; Song, K.; Zhao, F.; Liu, D.; Nie, L.; Lu, X. On the dose of plasma medicine: Plasma-activated medium (PAM) and its effect on cell viability. Phys. Plasmas 2022, 29, 063506. [Google Scholar] [CrossRef]
- Hu, X.; Zhang, Y.; Wu, R.A.; Liao, X.; Liu, D.; Cullen, P.J.; Zhou, R.-W.; Ding, T. Diagnostic analysis of reactive species in plasma-activated water (PAW): Current advances and outlooks. J. Phys. D Appl. Phys. 2022, 55, 023002. [Google Scholar] [CrossRef]
- Guo, L.; Xu, R.B.; Gou, L.; Liu, Z.C.; Zhao, Y.M.; Liu, D.X.; Zhang, L.; Chen, H.; Kong, M.G. Mechanism of Virus Inactivation by Cold Atmospheric-Pressure Plasma and Plasma-Activated Water. Appl. Environ. Microbiol. 2018, 84, e00726-18. [Google Scholar] [CrossRef]
- Li, Y.; Nie, L.; Liu, D.; Kim, S.; Lu, X. Plasma-activated chemical solutions and their bactericidal effects. Plasma Process. Polym. 2022, 19, 2100248. [Google Scholar] [CrossRef]
- Liu, K.; Liu, S.; Ran, C. The Effect of Air-Water-Plasma-Jet-Activated Water on Penicillium: The Reaction of HNO2 and H2O2 under Acidic Condition. Front. Phys. 2020, 8, 242. [Google Scholar] [CrossRef]
- Du, M.; Xu, H.; Zhu, Y.; Ma, R.; Jiao, Z. A comparative study of the major antimicrobial agents against the yeast cells on the tissue model by helium and air surface micro-discharge plasma. AIP Adv. 2020, 10, 025036. [Google Scholar] [CrossRef]
- Wang, Y.; Li, B.; Shang, H.; Ma, R.; Zhu, Y.; Yang, X.; Ju, S.; Zhao, W.; Sun, H.; Zhuang, J.; et al. Effective inhibition of fungal growth, deoxynivalenol biosynthesis and pathogenicity in cereal pathogen Fusarium spp. by cold atmospheric plasma. Chem. Eng. J. 2022, 437, 135307. [Google Scholar] [CrossRef]
- Li, H.; Bai, G.J.; Wu, J.; Yang, H.Q.; Zou, W. Ultraviolet-atmospheric and room temperature plasma combined mutagenesis of cellulase-producing fungi. Food Ferment. Ind. 2019, 45, 81–86. [Google Scholar]
- Jiang, G.; Yang, Z.; Wang, Y.; Yao, M.; Chen, Y.; Xiao, W.; Yuan, Y. Enhanced astaxanthin production in yeast via combined mutagenesis and evolution. Biochem. Eng. J. 2020, 156, 107519. [Google Scholar] [CrossRef]
- Jin, J.; Jia, B.; Yuan, Y.-J. Combining nucleotide variations and structure variations for improving astaxanthin biosynthesis. Microb. Cell Factories 2022, 21, 79. [Google Scholar] [CrossRef] [PubMed]
- Zhou, K.; Yu, C.; Liang, N.; Xiao, W.; Wang, Y.; Yao, M.; Yuan, Y. Adaptive Evolution and Metabolic Engineering Boost Lycopene Production in Saccharomyces cerevisiae via Enhanced Precursors Supply and Utilization. J. Agric. Food Chem. 2023, 71, 3821–3831. [Google Scholar] [CrossRef] [PubMed]
- Xu, H.H.; Zhang, H.B.; Li, H.X.; Li, L. The application progress of atmospheric and room temperature plasma technology in microbial mutagenesis. Adv. Biotechnol. 2020, 10, 358–362. [Google Scholar]
- Cai, M.; Wu, Y.; Qi, H.; He, J.; Wu, Z.; Xu, H.; Qiao, M. Improving the Level of the Tyrosine Biosynthesis Pathway in Saccharomyces cerevisiae through HTZ1 Knockout and Atmospheric and Room Temperature Plasma (ARTP) Mutagenesis. ACS Synth. Biol. 2021, 10, 49–62. [Google Scholar] [CrossRef] [PubMed]
- Xu, X.; Niu, C.; Liu, C.; Wang, J.; Zheng, F.; Li, Q. A Novel Approach to Develop Lager Yeast with Higher NADH Availability to Improve the Flavor Stability of Industrial Beer. Foods 2021, 10, 3057. [Google Scholar] [CrossRef] [PubMed]
- Tian, T.; Wu, D.; Ng, C.-T.; Yang, H.; Sun, J.; Liu, J.; Lu, J. A multiple-step strategy for screening Saccharomyces cerevisiae strains with improved acid tolerance and aroma profiles. Appl. Microbiol. Biotechnol. 2020, 104, 3097–3107. [Google Scholar] [CrossRef] [PubMed]
- Guo, J.; Luo, W.; Wu, X.-M.; Fan, J.; Zhang, W.-X.; Suyama, T. Improving RNA content of salt-tolerant Zygosaccharomyces rouxii by atmospheric and room temperature plasma (ARTP) mutagenesis and its application in soy sauce brewing. World J. Microbiol. Biotechnol. 2019, 35, 180. [Google Scholar] [CrossRef]
- Xu, Z.; Wei, J.; Shen, J.; Liu, Y.; Ma, R.; Zhang, Z.; Qian, S.; Ma, J.; Lan, Y.; Zhang, H.; et al. Genetic effects of an air discharge plasma on Staphylococcus aureus at the gene transcription level. Appl. Phys. Lett. 2015, 106, 213701. [Google Scholar] [CrossRef]
- Woods, R.; Schneider, D.; Winkworth, C.L.; Riley, M.A.; Lenski, R.E. Tests of parallel molecular evolution in a long-term experiment with Escherichia coli. Proc. Natl. Acad. Sci. USA 2006, 103, 9107–9112. [Google Scholar] [CrossRef]
- Barrick, J.E.; Yu, D.S.; Yoon, S.H.; Jeong, H.; Oh, T.K.; Schneider, D.; Lenski, R.E.; Kim, J.F. Genome evolution and adaptation in a long-term experiment with Escherichia coli. Nature 2009, 461, 1243–1247. [Google Scholar] [CrossRef]
- Shen, X.; Song, S.; Li, C.; Zhang, J. Synonymous mutations in representative yeast genes are mostly strongly non-neutral. Nature 2022, 606, 725–731. [Google Scholar] [CrossRef] [PubMed]
- Pazmiño, D.T.; Winkler, M.; Glieder, A.; Fraaije, M. Monooxygenases as biocatalysts: Classification, mechanistic aspects and biotechnological applications. J. Biotechnol. 2010, 146, 9–24. [Google Scholar] [CrossRef] [PubMed]
- Tao, L.; Fu, S.X. Research progress of arachidonic acid and oxidative stress. Chin. J. Pathophysiol. 2011, 27, 2233–2236. [Google Scholar]
- Xu, Z.X.; Zhu, Y.G.; Li, S.; Cheng, Z. Bioinformatics Analysis of NADPH-Cytochrome P450 Reductase Genes in Cordyceps sinensis. Fungi Res. 2021, 19, 54–62. [Google Scholar]
- Maseme, M.J.; Pennec, A.; van Marwijk, J.; Opperman, D.J.; Smit, M.S. CYP505E3: A Novel Self-Sufficient ω-7 In-Chain Hydroxylase). Angew. Chem.—Int. Ed. 2020, 59, 10359–10362. [Google Scholar] [CrossRef] [PubMed]
- Zhang, L.N.; Dong, L.; Liao, H.M. Survival strategies and related research progress of bacteria in response to excessive reactive oxygen species. Microbiol. Bull. 2021, 48, 1249–1259. [Google Scholar]
- Sies, H. Oxidative Stress: Concept and Some Practical Aspects. Antioxidants 2020, 9, 852. [Google Scholar] [CrossRef]
- Sies, H.; Jones, D.P. Reactive oxygen species (ROS) as pleiotropic physiological signalling agents. Nat. Rev. Mol. Cell Biol. 2020, 21, 363–383. [Google Scholar] [CrossRef]

| H2O2 (mg/L) | NO2− (mg/L) | NO3− (mg/L) | |
|---|---|---|---|
| PAW | 48.76 | 0.046 | 172.36 |
| pH | Conductivity (µS/cm) | ORP (mV) | |
|---|---|---|---|
| sterile water | 6.39 | 7.15 | 407.27 |
| PAW | 2.42 | 1935 | 517.07 |
| CAW | 6.15 | - | 301.73 |
| Treatment Time (min) | 30 min | 60 min | 90 min |
|---|---|---|---|
| PAW probable mutation rate | 30.30% | 30.50% | 33.30% |
| CAW probable mutation rate | 0 | 0 | 0.33% |
| Strain Name | HC Value | Filter Paper Enzyme Activity (U/mL) | Cellulose Endonuclease Activity (U/mL) | β-Glucosidase Enzyme Activity (U/mL) |
|---|---|---|---|---|
| original strain | 3.33 | 22.48 h | 9.96 D | 26.55 f |
| A-WW1 | 4.50 | 24.54 g | 11.55 B | 28.16 c |
| A-WW2 | 5.50 | 25.62 f | 9.86 E | 29.83 b |
| A-WW3 | 4.50 | 25.46 e | 10.12 C | 30.20 a |
| A-WW4 | 3.50 | 25.98 d | 8.63 F | 22.48 h |
| A-WW5 | 5.50 | 29.66 a | 13.78 A | 27.13 e |
| A-WW6 | 4.51 | 28.45 c | 8.32 G | 24.57 g |
| A-WW7 | 4.00 | 29.33 b | 7.62 H | 27.56 d |
| Strain Name | HC Value | Filter Paper Enzyme Activity (U/mL) | Cellulose Endonuclease Activity (U/mL) | β-Glucosidase Enzyme Activity (U/mL) |
|---|---|---|---|---|
| original strain | 3.33 | 22.48 a | 9.96 A | 26.55 a |
| C-WW1 | 3.50 | 21.33 d | 9.54 D | 24.32 d |
| C-WW2 | 3.51 | 21.44 c | 9.57 C | 24.35 c |
| C-WW3 | 4.00 | 22.47 b | 9.69 B | 24.40 b |
| C-WW4 | 3.33 | 20.36 f | 6.32 G | 19.37 h |
| C-WW5 | 3.50 | 20.37 f | 6.59 F | 19.44 g |
| C-WW6 | 3.33 | 19.88 g | 6.72 E | 20.34 f |
| C-WW7 | 3.35 | 20.52 e | 6.32 G | 21.24 e |
| Sample Number | CDS Coding Region Non-Synonymous Mutations (Number) | CDS Coding Region Synonymous Mutation (Number) | Non-Coding Region (Number) | Total (Number) |
|---|---|---|---|---|
| A-WW5 | 56 | 13 | 47 | 116 |
| A↔T | G↔C | A↔C | G↔T | A↔G | T↔C | |
|---|---|---|---|---|---|---|
| CDS coding region | 8 | 9 | 11 | 7 | 18 | 16 |
| Non-coding region | 7 | 9 | 9 | 6 | 7 | 9 |
Disclaimer/Publisher’s Note: The statements, opinions and data contained in all publications are solely those of the individual author(s) and contributor(s) and not of MDPI and/or the editor(s). MDPI and/or the editor(s) disclaim responsibility for any injury to people or property resulting from any ideas, methods, instructions or products referred to in the content. |
© 2024 by the authors. Licensee MDPI, Basel, Switzerland. This article is an open access article distributed under the terms and conditions of the Creative Commons Attribution (CC BY) license (https://creativecommons.org/licenses/by/4.0/).
Share and Cite
Song, Z.; Jiang, Y.; Chen, C.; Ding, C.; Chen, H. Effect of Plasma-Activated Water on the Cellulase-Producing Strain Aspergillus niger A32. J. Fungi 2024, 10, 568. https://doi.org/10.3390/jof10080568
Song Z, Jiang Y, Chen C, Ding C, Chen H. Effect of Plasma-Activated Water on the Cellulase-Producing Strain Aspergillus niger A32. Journal of Fungi. 2024; 10(8):568. https://doi.org/10.3390/jof10080568
Chicago/Turabian StyleSong, Zhiqing, Yingwei Jiang, Chan Chen, Changjiang Ding, and Hao Chen. 2024. "Effect of Plasma-Activated Water on the Cellulase-Producing Strain Aspergillus niger A32" Journal of Fungi 10, no. 8: 568. https://doi.org/10.3390/jof10080568
APA StyleSong, Z., Jiang, Y., Chen, C., Ding, C., & Chen, H. (2024). Effect of Plasma-Activated Water on the Cellulase-Producing Strain Aspergillus niger A32. Journal of Fungi, 10(8), 568. https://doi.org/10.3390/jof10080568

